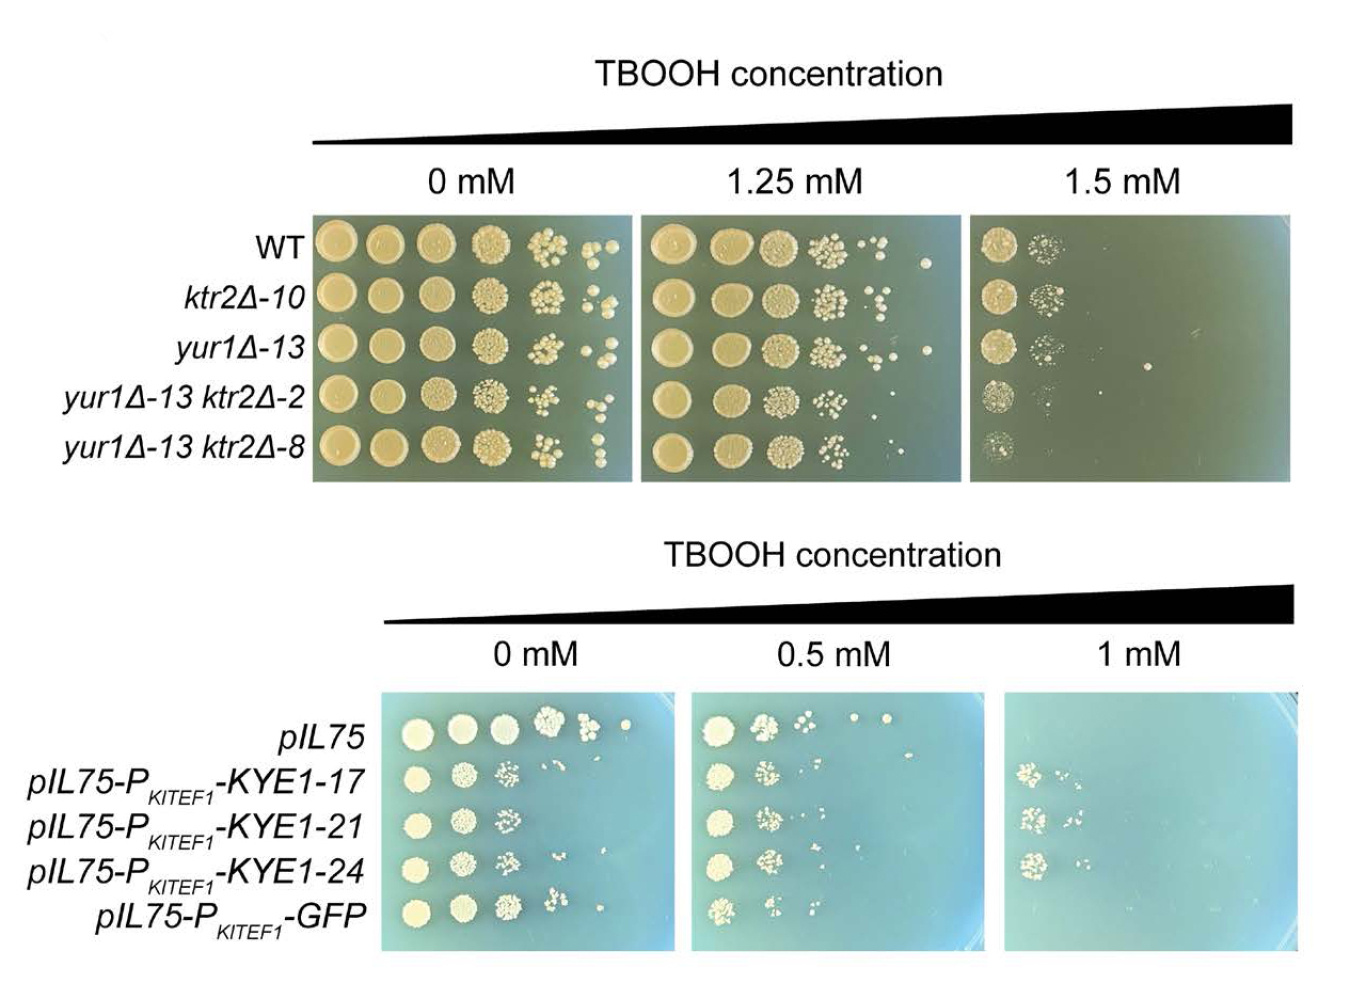

Study provides a framework for connecting genetic mechanisms and trait variation across diverse yeast species.
Biological and Environmental Research
September 29, 2025The Science
Reactive oxygen species (ROS) are unstable molecules that organisms create during natural functions. These functions include breathing and converting food into energy. During industrial processes, yeasts are often exposed to high levels of ROS. This exposure can limit the amount of high-value fatty acids or other bioproducts the yeasts can make. Some yeasts are naturally resistant to oxidative stress. However, scientists have limited knowledge of which species are resistant or how they protect themselves. Here, scientists used machine learning to analyze the genetic blueprints of hundreds of yeasts. This analysis allowed them to identify which groups of genes are most important for ROS resistance.
The Impact
Identifying the genetic factors related to oxidative stress resistance can help scientists understand how these functions evolved. The study highlights genes that scientists could target to make more robust strains of yeast for industrial uses. These uses include making biofuels or bioproducts. In addition, researchers may be able to use this information to fight yeast infections. The work also provides a framework for using machine learning to identify genes related to traits across many species.
Summary
Scientists with the Great Lakes Bioenergy Research Center tested 285 yeasts across the subphylum Saccharomycotina to evaluate the group’s variance in ROS resistance. They then trained a machine learning model to identify the genes most important for resistance. The model identified two groups of important genes. One of these groups helps build and maintain the cell wall. The other group consists of reductase genes that produce an enzyme to neutralize ROS.
To validate the predictions, the scientists did two experiments. First, they took a species highly susceptible to ROS, K. lactis. The researchers gave it an extra copy of the reductase gene to increase production of the relevant enzyme. The modified yeast was more resistant to ROS. Researchers then deleted two genes responsible for cell wall construction from a second species, Saccharomyces cerevisiae. This deletion made that yeast more susceptible to ROS stress. These experiments show that we can draw connections between machine learning model predictions and benchtop biology.
Contact
Chris Todd Hittinger
University of Wisconsin–Madison
cthittinger@wisc.edu
Funding
This project was supported by the Great Lakes Bioenergy Research Center, U.S. Department of Energy, Office of Science, Biological and Environmental Research Program; the National Science Foundation; the National Institute of Food and Agriculture, United States Department of Agriculture; National Institutes of Health/National Institute of Allergy and Infectious Diseases; and the Burroughs Wellcome Fund.
Publications
Aranguiz, K., et al., Machine learning reveals genes impacting oxidative stress resistance across yeasts. Nature Communications, 16, 1–15. (2025). [DOI:10.1038/s41467-025-60189-3]